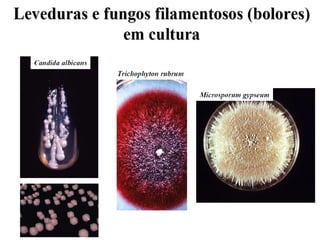
Aula   11 fungos

O documento resume as principais características dos fungos, incluindo sua estrutura celular, reprodução, nutrição, classificação e importância médica. Aborda os tipos de hifas, esporos e formas de classificação de fungos, além de mencionar exemplos de micoses e métodos de diagnóstico laboratorial.